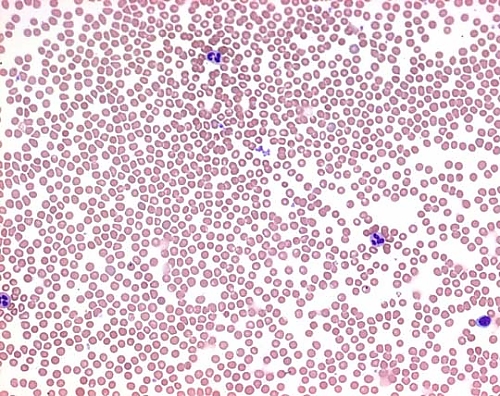
Incident ID: 4399d7a9-bohn-4cb5-bf85-6525dca75a75 IP Address : 219.104.25.38

【 特別 送料無料 】 1本たったの598円(税込) 3大銘醸地入り 世界選りすぐり赤ワイン11本セット 第275弾【7784795】 | 金賞 飲み比べ ワイン ワインセット wine…

臨床検査用染色液・試薬及び顕微鏡用グラス、替刃等に貢献する武藤化学株式会社

H&E Staining Kit (Hematoxylin and Eosin) ab245880
![キリン 淡麗グリーンラベル(350ml*48本セット)【kb8】【kb4】【kh0】【淡麗グリーンラベル】[発泡酒 糖質オフ]](https://thumbnail.image.rakuten.co.jp/@0_mall/soukaidrink/cabinet/522/62522.jpg?_ex=300x300)
キリン 淡麗グリーンラベル(350ml*48本セット)【kb8】【kb4】【kh0】【淡麗グリーンラベル】[発泡酒 糖質オフ]

臨床検査用染色液・試薬及び顕微鏡用グラス、替刃等に貢献する武藤化学株式会社
![アサヒ スーパードライ 缶(350ml*48本セット)【アサヒ スーパードライ】[アサヒビール/ビール/スーパードライ]](https://thumbnail.image.rakuten.co.jp/@0_mall/soukaidrink/cabinet/557/62557.jpg?_ex=300x300)
アサヒ スーパードライ 缶(350ml*48本セット)【アサヒ スーパードライ】[アサヒビール/ビール/スーパードライ]
Incident ID: 4399d7a9-bohn-4cb5-bf85-6525dca75a75 IP Address : 219.104.25.38

【30%OFF!10,120円 → 7,084円!】スパークリングワイン セット 辛口 ワインセット 泡 ワイン ギフト 箱 京橋ワイン 京橋わいん 9本 750ml 飲み比べ フランス 送料無料…